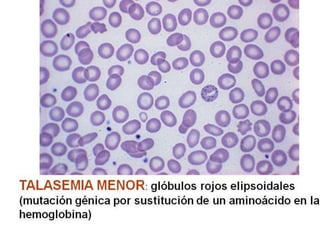

El documento describe conceptos básicos de genética. Explica que el ADN se encuentra en el núcleo de las células eucariotas y se organiza en cromosomas. El ADN se transcribe en ARN que luego se traduce en proteínas. Las células contienen 46 cromosomas agrupados en 22 pares autosómicos y un par sexual. Las mutaciones pueden ser cromosómicas, alterando el número o estructura de cromosomas, o puntuales, cambiando la secuencia de nucleótidos de un gen.